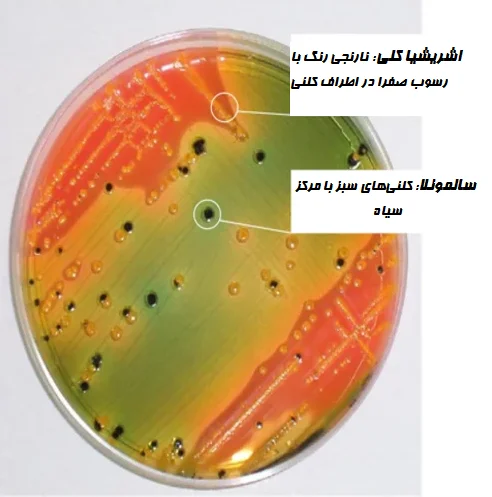
تفسیر نتایج در محیط کشت HE

فهرست مطالب
نمایش
- هکتون انتریک آگار یک محیط انتخابی و افتراقی است که برای جداسازی و افتراق گونههای سالمونلا (Salmonella) و شیگلا (Shigella) از سایر باکتریهای خانواده انتروباکتریاسه (Enterobacteriaceae) طراحی شده است.
- این محیط در سال 1968 توسط Sylvia King و William I. Metzger معرفی شد. آنها در حین کار در مؤسسه Hektoen در شیکاگو، محیط کشت هکتون انتریک آگار را برای افزایش بازیابی سالمونلا و شیگلا از نمونههای بالینی، فرموله کردند.
ترکیبات هکتون انتریک آگار
| اجزاء ترکیب | گرم در لیتر |
| پروتئاز پپتون (Protease peptone) | 12 |
| عصاره مخمر | 3 |
| لاکتوز (Lactose) | 12 |
| ساکارز (Sucrose) | 2 |
| سالیسین (Salicin) | 9 |
| مخلوط نمکهای صفراوی | 9 |
| کلرید سدیم | 5 |
| تیوسولفات سدیم (Sodium thiosulfate) | 5 |
| سیترات آمونیوم فریک (Ferric ammonium citrate) | 1.5 |
| اسید فوشین (Acid fuchsin) | 0.1 |
| بروموتیمول بلو (Bromothymol blue) | 0.065 |
| آگار | 14 |
pH نهایی (در دمای 25 درجه سانتیگراد): 0.2±7.5
اصول محیط کشت HE
- هکتون انتریک آگار محیطی است که به استفاده از نمکهای صفراوی برای مهار انتخابی و دو سیستم اندیکاتوری متکی است:
- بروموتیمول بلو و اسید فوشین به عنوان اندیکاتورهای کاتابولیسم کربوهیدرات.
- آهن فریک به عنوان اندیکاتور تشکیل سولفید هیدروژن (Hydrogen sulfide) از تیوسولفات.
- HE آگار باعث رشد خوب شیگلا میشود، زیرا مهار این ارگانیسمها توسط نمکهای صفراوی با افزودن مقادیر نسبتاً زیاد پپتون و کربوهیدراتها کاهش مییابد.
- این محیط افتراق کلنی خوبی را فراهم کرده، برخی از کلیفرمها و سایر باکتریهای غیر تخمیرکننده لاکتوز را مهار و در نتیجه شناسایی سالمونلا و شیگلا را از محصولات غذایی تسهیل میکند.
- HE آگار از پپتون پروتئوز، عصاره مخمر، کلرید سدیم، لاکتوز، ساکارز، سالیسین، برموتیمول بلو، اسید فوشین، تیوسولفات سدیم، سیترات آمونیوم آهن (III)، نمکهای صفراوی، آگار و آب مقطر یا دیونیزه تشکیل شده است.
- در HE آگار، باکتریهای سالمونلا کلنیهای سبز یا آبی-سبز شفاف با یا بدون مراکز سیاه تولید میکنند و تقریباً به صورت کلنیهای کاملاً سیاه ظاهر میشوند.
- شیگلا کلنیهای سبز و شفاف تولید میکند. از آنجایی که سایر ارگانیسمها کلونیهای مشابه سالمونلا و شیگلا تشکیل میدهند، آزمایشهای تاییدی بیوشیمیایی و سرولوژیکی ضروری است.
- باکتریهای گرم منفی تخمیر کننده لاکتوز، ساکارز یا سالیسین، کلونیهایی به رنگ ماهی سالمون (رنگ صورتی روشن) تولید میکنند.
آمادهسازی و روش استفاده از هکتون انتریک آگار
- 66 گرم از محیط را در 1000 میلیلیتر آب تصفیه شده / مقطر بریزید.
- آن را حرارت داده تا به جوش آید و محیط کاملا حل شود.
توجه: محیط را اتوکلاو نکنید.
- آن را تا دمای 45 تا 50 درجه سانتیگراد خنک کنید.
- محیط را خوب مخلوط کرده و در پلیتهای پتری (Petri plate) استریل بریزید.
- محیط را با مدفوع تازه ساسپند شده در محلول رینگر (Ringer) تلقیح کنید یا این که محیط را مستقیماً با سواب رکتوم تلقیح کنید.
- تلقیح را پخش کنید تا کلنیها به خوبی از هم جدا شوند.
- به مدت 18 تا 24 ساعت در دمای 37 درجه سانتیگراد انکوبه کنید.
- انکوباسیون بیشتر، افتراق بین سالمونلا و شیگلا را بهبود میبخشد.
تفسیر نتایج در HE آگار
- تخمیرکنندههای سریع لاکتوز (مانند coli) تا حدودی مهار میشوند و کلنیهایی به رنگ نارنجی روشن تا صورتی سالمون تولید میکنند.
- کلنیهای سالمونلا به رنگ سبز مایل به آبی معمولاً با مراکز سیاه رنگ مربوط به گاز سولفید هیدروژن هستند.
- شیگلا سبزتر از سالمونلا به نظر میرسد و رنگ آن در حاشیه کلنی محو میشود.
- سویههای پروتئوس (Proteus) تا حدودی مهار میشوند. کلنیهایی که رشد میکنند نسبت به گونههای سالمونلا یا شیگلا، شفاف و کوچک هستند و از نظر ظاهری براقتر یا آبکیتر هستند.
| ارگانیسم | رشد |
| سالمونلا تیفی موریوم (Salmonella Typhimurium) | کلنیهای آبی سبز با یا بدون مراکز سیاه |
| سالمونلا آبونی (Salmonella Abony) | کلنیهای آبی سبز با یا بدون مرکز سیاه |
| سالمونلا انتریتیدیس (Salmonella Enteritidis) | کلنیهای آبی سبز با یا بدون مرکز سیاه |
| سالمونلا تیفی (Salmonella Typhi) | کلنیهای آبی سبز با یا بدون مرکز سیاه |
| اشریشیا کلی (Escherichia coli) | کلنیهای نارنجی (ممکن است رسوب صفرا داشته باشد) |
| شیگلا فلکسنر (Shigella flexneri) | کلنیهای آبی مایل به سبز |
| شیگلا سونئی (Shigella sonnei) | رشد خوب تا عالی؛ کلنیهای سبز روشن |
| پروتئوس | کلنیهای آبی سبز تا آبی یا صورتی سالمون، و در اکثر سویهها با مراکز سیاه یا کاملاً سیاه |
| انتروباکتر (Enterobacter)/ کلبسیلا (Klebsiella) | کلنیهای بزرگ به رنگ زرد تا صورتی سالمون |
موارد استفاده از هکتون انتریک آگار
- محیط کشت هکتون انتریک آگار برای جداسازی افتراقی و انتخابی گونههای سالمونلا و شیگلا از نمونههای پاتولوژیک روده مطابق با فارماکوپه ایالات متحده، توصیه شده است.
- این محیط توسط فارماکوپه 2009 ایالات متحده برای تست وجود سالمونلا در مکملهای رژیمی توصیه شده است.
- این محیط در تست حضور سالمونلا در نمونههای غذایی با استانداردهای مختلف توصیه شده است.
- HE آگار در حال حاضر به عنوان یک محیط کشت پلیت مستقیم و غیرمستقیم برای نمونههای مدفوع به منظور افزایش بازیابی گونههای سالمونلا و شیگلا از میان تعداد زیادی فلور (Flora) طبیعی مدفوعی، استفاده میشود.
- از این آگار به عنوان یک محیط کشت پلیت برای بازیابی پاتوژنهای دستگاه گوارش مانند سالمونلا و شیگلا از غذا، آب و نمونههای مدفوع مشکوک به وجود این ارگانیسمها، استفاده میشود.
محدودیتهای هکتون انتریک آگار
- استفاده از تنها یک محیط کشت به ندرت قادر به بازیابی همه پاتوژنهای موجود در یک نمونه است. بنابراین محیطهای بیشتری برای جداسازی سالمونلا و یا شیگلا و احتمالاً سایر پاتوژنهای رودهای باید با نمونه تلقیح شود.
- کلنیهای پروتئوس میرابیلیس (Proteus mirabilis) در این محیط ممکن است شبیه کلنیهای سالمونلا باشند.
- برخی از سویههای شیگلا ممکن است به انکوباسیون 42 تا 48 ساعته نیاز داشته باشند.
- اگرچه آزمایشهای تشخیصی خاصی ممکن است مستقیماً بر روی این محیط انجام شود، آزمایشات بیوشیمیایی و در صورت لزوم ایمونولوژیک با استفاده از کشتهای خالص برای شناسایی کامل ضروری است.
- کلنیهایی که مشکوک به سالمونلا یا شیگلا هستند باید از نظر بیوشیمیایی و سرولوژیکی تایید و شناسایی شوند.
جهت خرید و یا استعلام قیمت با ما تماس بگیرید یا در واتسپ پیام بزارید
همچنین بخوانید:
- محیط کشت CVA (کمپیلوباکتر بلاد آگار): ترکیب، اصول، آمادهسازی، نتایج و کاربرد
- زاپکس آگار (محیط کشت CZA): ترکیب، اصول، آمادهسازی، نتایج و کاربرد
- محیط کشت BSA: ترکیب، اصول، آمادهسازی، نتایج و کاربرد
- محیط کشت DCA: ترکیب، اصول، روش آمادهسازی، نتایج و کاربرد
مترجم: صادق حسینیکیا



